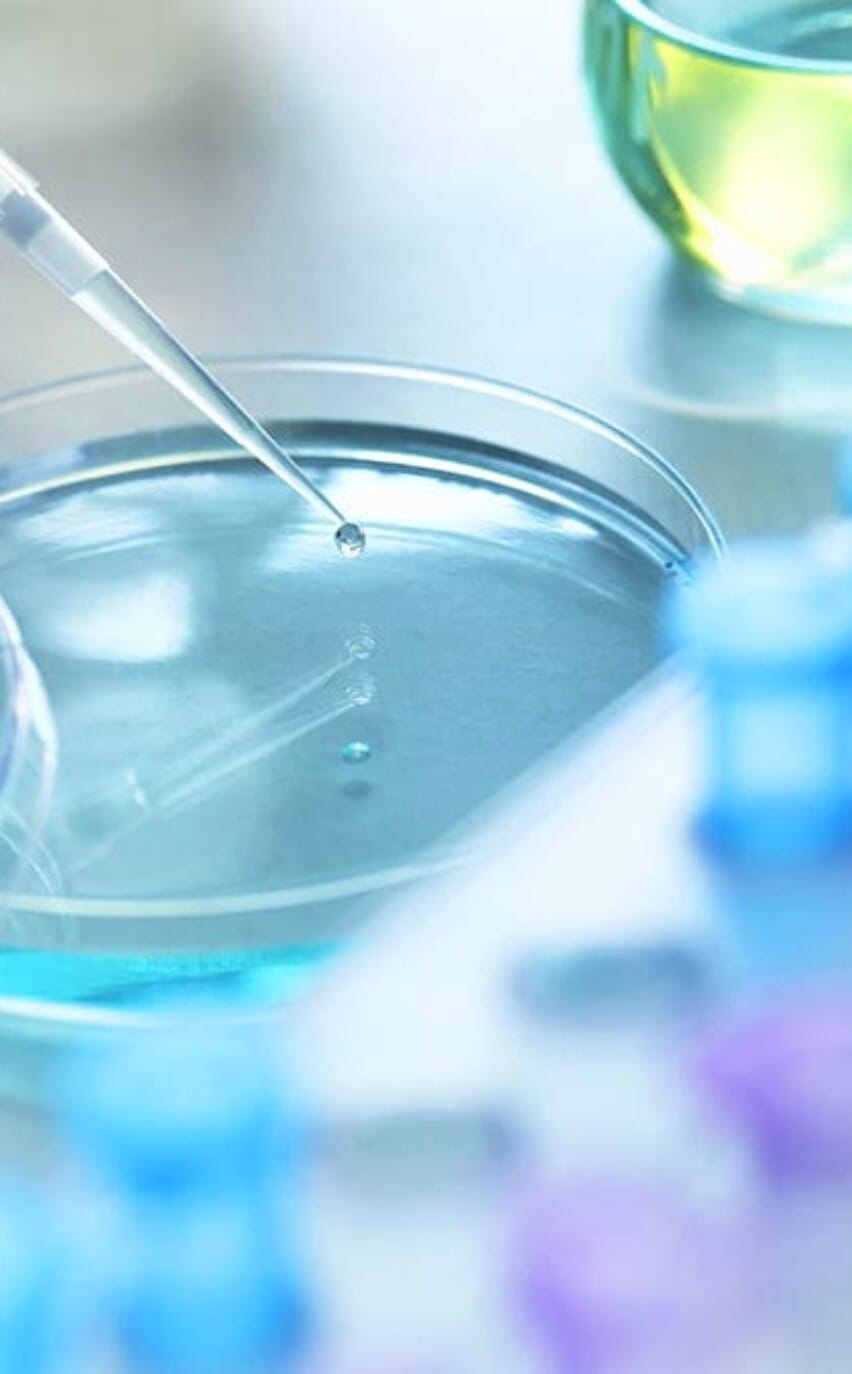

MNT
Supercritical Extracted Organic Hemp Terp with a Mint top note.
Middle and base notes arouse with watermint, spearmint and peppermint.





DESCRIPTION
Epic THC has developed the perfect pairing of THC distillate and Hemp Terpineols. Our unique and proprietary formulation for MNT is a fresh take on a customer favourite vaping experience. Both spearmint and peppermint have a sweet, refreshing flavor accompanied by a cooling sensation and a distinctive scent with eucalyptus qualities. Peppermint is a hybrid of spearmint and watermint but its scent is more pungent and its flavor sharper than that of either parent.
Each hit of MNT begs for a second or third hit. In an industry dominated by subpar and often terrible vaping experiences, EPIC is set to take your vape cartridge to the moon. Its not complicated, there is no ambiguity. Try it. Try you vape next to a vape blended with MNT. Do a blind taste test with your staff and customers. We guarantee 100% of the time they will choose the EPIC terpineol blend over any other on the market.
FOOD GRADE : YES
KOSHER : YES
GMO : NO
CA PROP 65 : NO
GMP : YES
TSCA : YES
USA NATURAL : NO
EUROPE NATURAL : NO
PROPERTIES
- Molecular Weight: 167.28
Assay/Purity: PURITY % 99.9-100 - Flash Point: 218°F (103°C)
Boiling Point: 174°C - Shelf Life: 60 MONTHS
Food Grade: YES
EFFECTS
- Calm Relaxation
Creative Flow - Entertainment Enhancer
Developed Appetite - Synapse Relaxer
Party Mood Booster
TERPINEOLS
- alpha-Bisabolol
Para-Cymene - beta-Pinene
Delta-3-Carene - Valencene
Limonene
CHEMISTRY EVOLVED
We don’t want to brag, but we’re gonna go ahead and say it anyway. We have 3 published PhD chemists on staff that work tirelessly around the clock to develop, create and invent new terpineols formulations for the hemp market. It is this dedication to the craft that makes us truly EPIC. A process that involves thousands of hours of development, testing and market research for each and every one of our products. As we strongly believe in quality over quantity, we only release a product when its simply the best on the market, period.
We are a leading supplier to the global hemp industry with solutions and services for research, terpineols development and production, and product enhancers. It is our goal to constantly reach for perfection with each and every product we create. Off the shelf or custom created, we work with each individual client to design and develop the perfect terpineol solution with each use case.
USE CASE
Specifically formulated to be effortlessly blended into THC distillate. Our terpineols are developed to give the vape manufacturer tremendous flexibility in the usage. We suggest at warm blend at 5% – 10% with little to no exposure to heat. Blent thoroughly and completely for homogeny. Once blended immediately inject into final vape cartridge. Do not store in the warm or cold area. Avoid exposure to air and light. Seal tightly and securely between uses. Wear gloves and masks when handling.